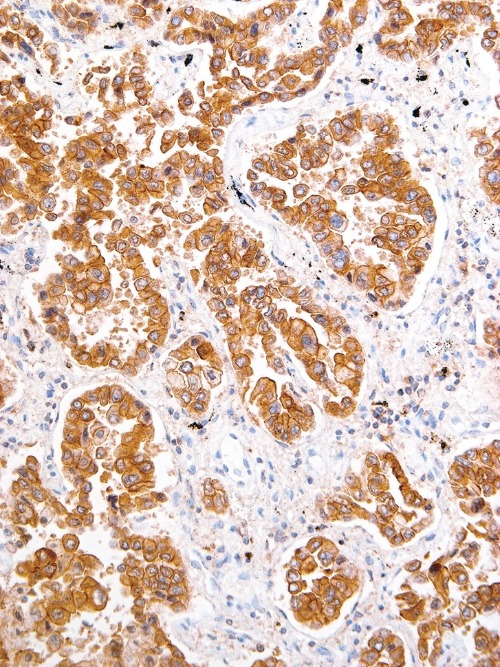

ROS1 Rabbit Monoclonal Antibody(ARM560)
CAT.NO. : ARM6850
RMB Please choose
RMB Please choose
Size:
Trail, Bulk size or Custom requests Please contact us
*产品价格可能会有所调整,请以品牌方官网实时更新的价格为准,以确保准确性。
Background
ROS1 serves as a receptor tyrosine kinase. Gene rearrangement events involving ROS1 have been described in lung and other cancers, and such tumours have been found to be remarkably responsive to small molecule tyrosine kinase inhibitors. Multiple studies have observed ROS1 gene rearragement events in approximately 1% of lung cancers and showed that inhibition of tumour cells bearing ROS1 gene fusions by crizotinib or other ROS1 tyrosine kinase inhibitors was effective in vitro.
Application
|
Application |
Dilution Ratio |
|
IHC |
1:25 - 1:100 |
Overview
|
OMIM |
165020 |
|
3D Structure |
ModBase 3D Structure for P08922 |
|
Isotype |
IgG |
|
Host |
Rabbit |
|
Species Reactivity |
Human |
|
Purity/Purification |
Purified |
|
Form/Format |
Tris Buffer, pH 7.3 - 7.7, with 1% BSA and <0.1% Sodium Azide |
|
Immunogen |
Recombinant Protein |
Data
Immunohistochemical staining of human lung cancer tissue using ROS1 Rabbit Monoclonal Antibody (ARM560).
Storage
Store at -20°C. Stable for one year from the date of shipment.
Research Use Only
For Research Use Only. Not for use in diagnostic procedures.
New Products
